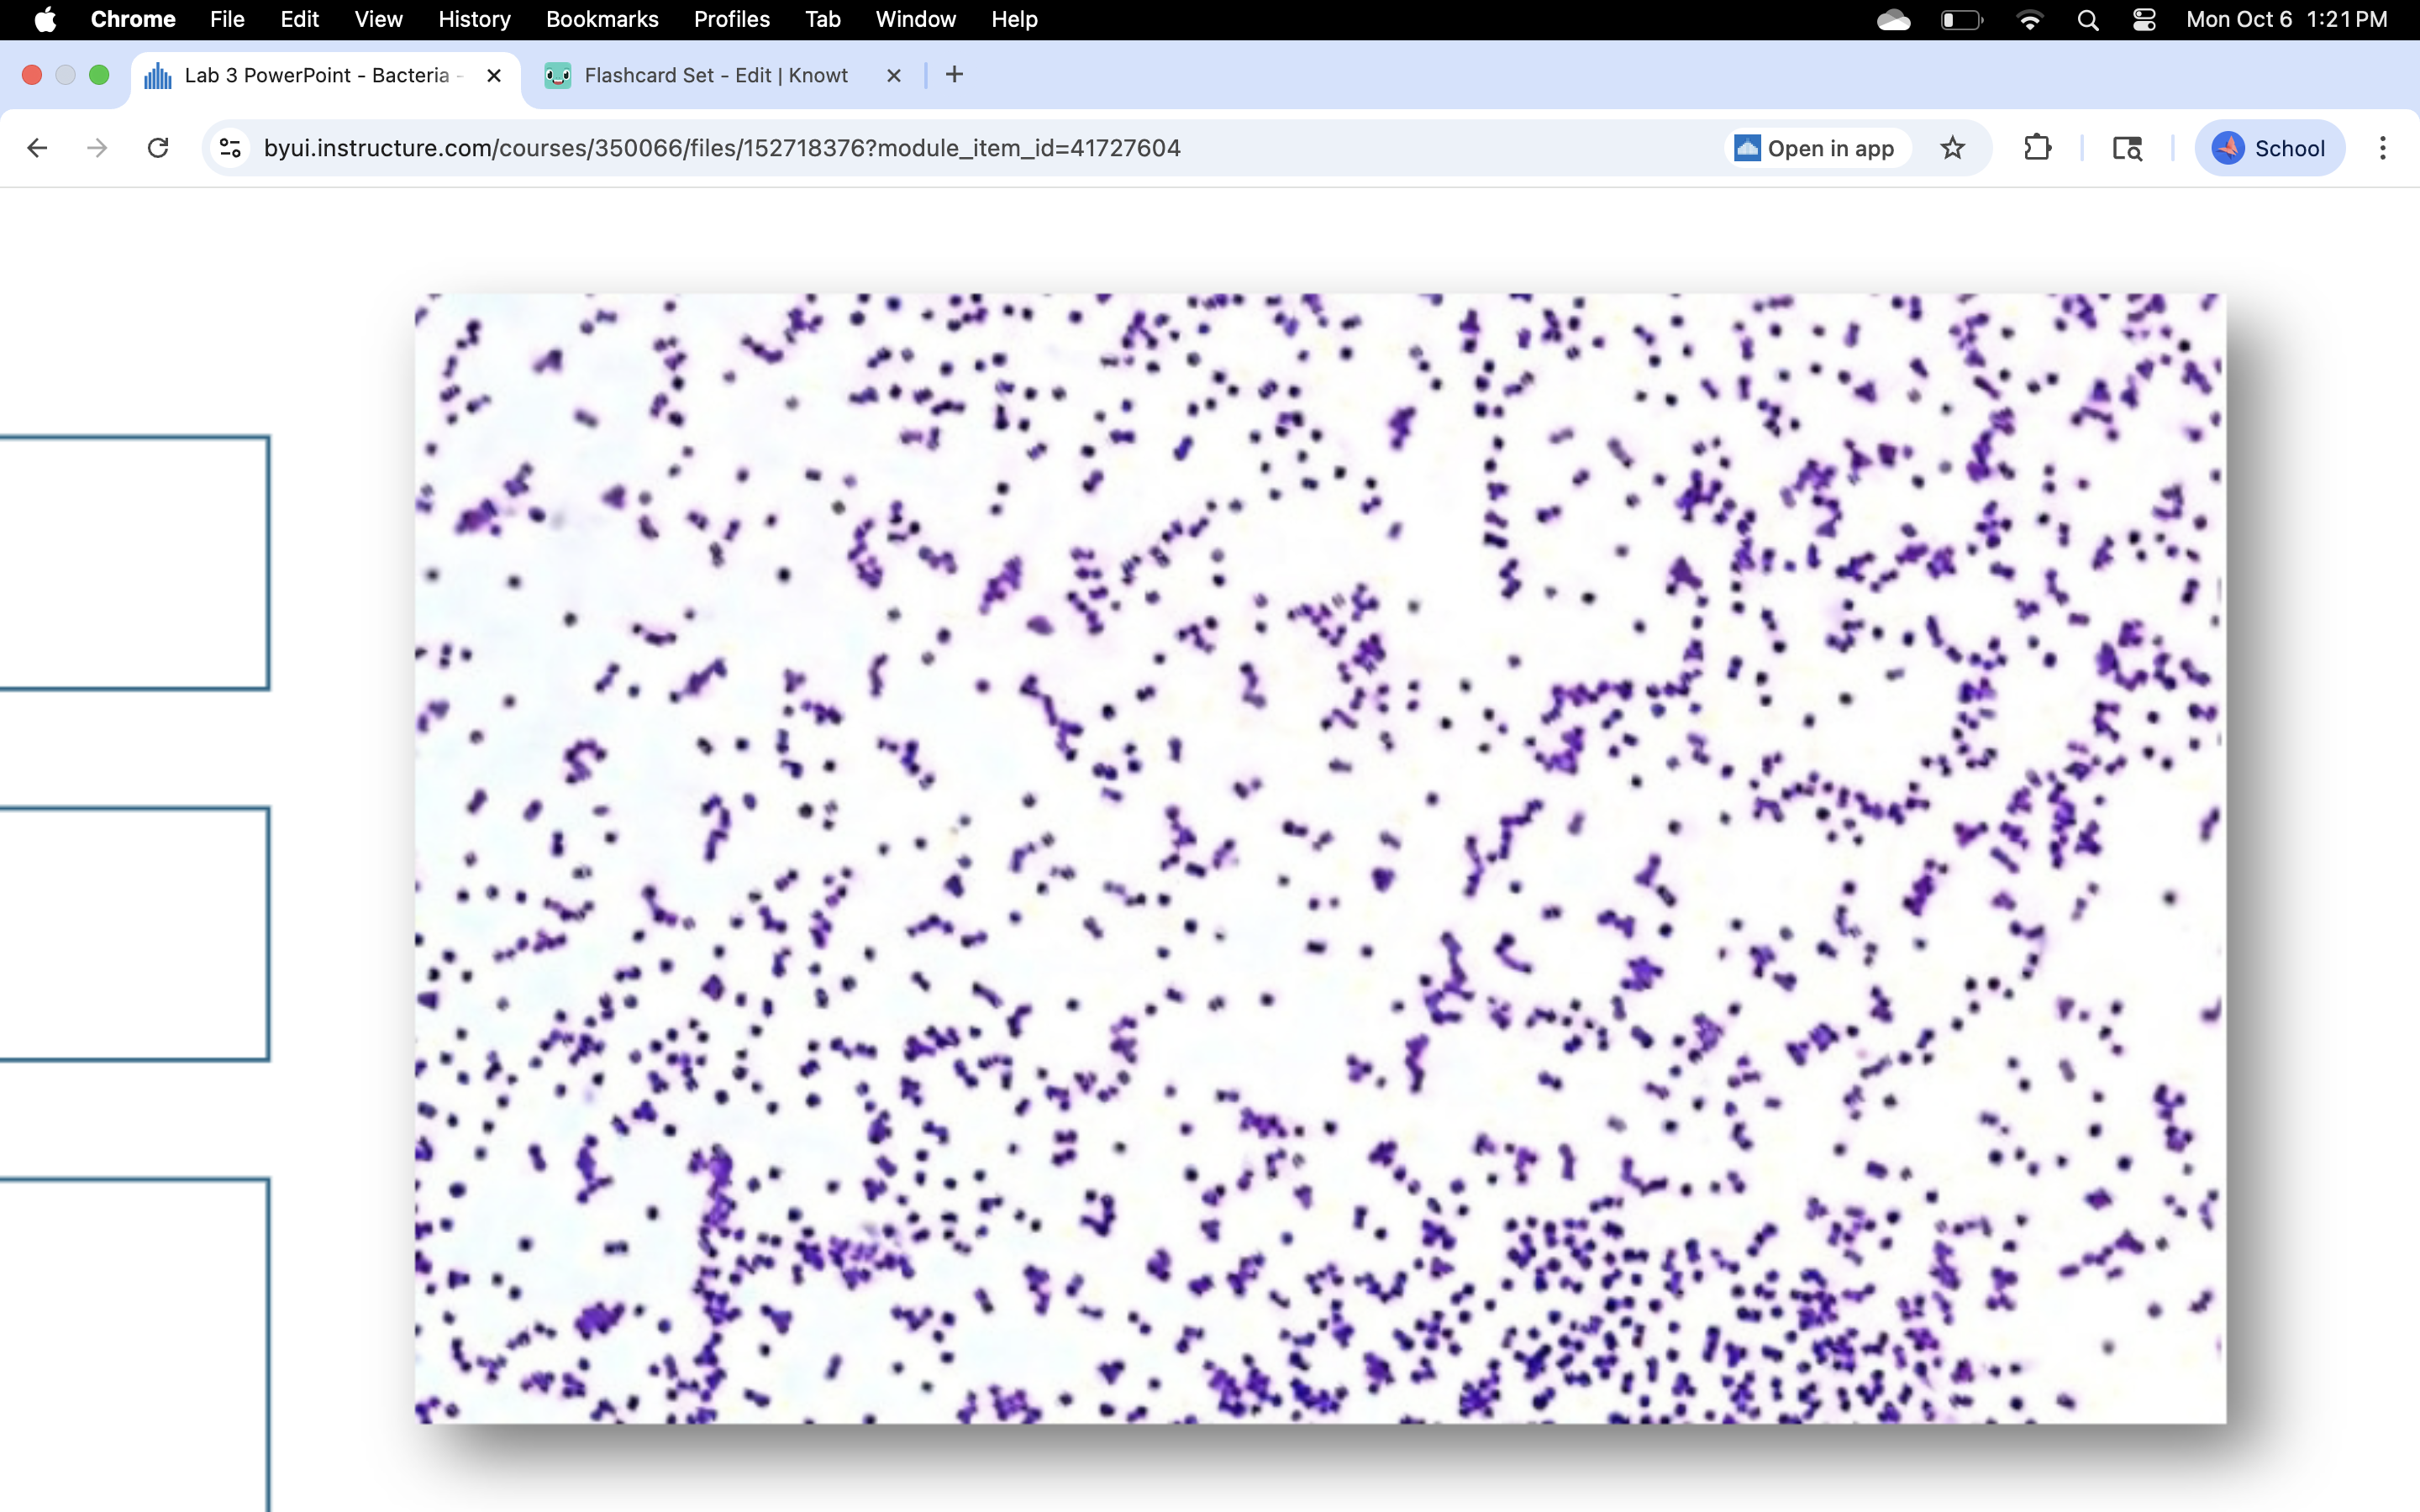
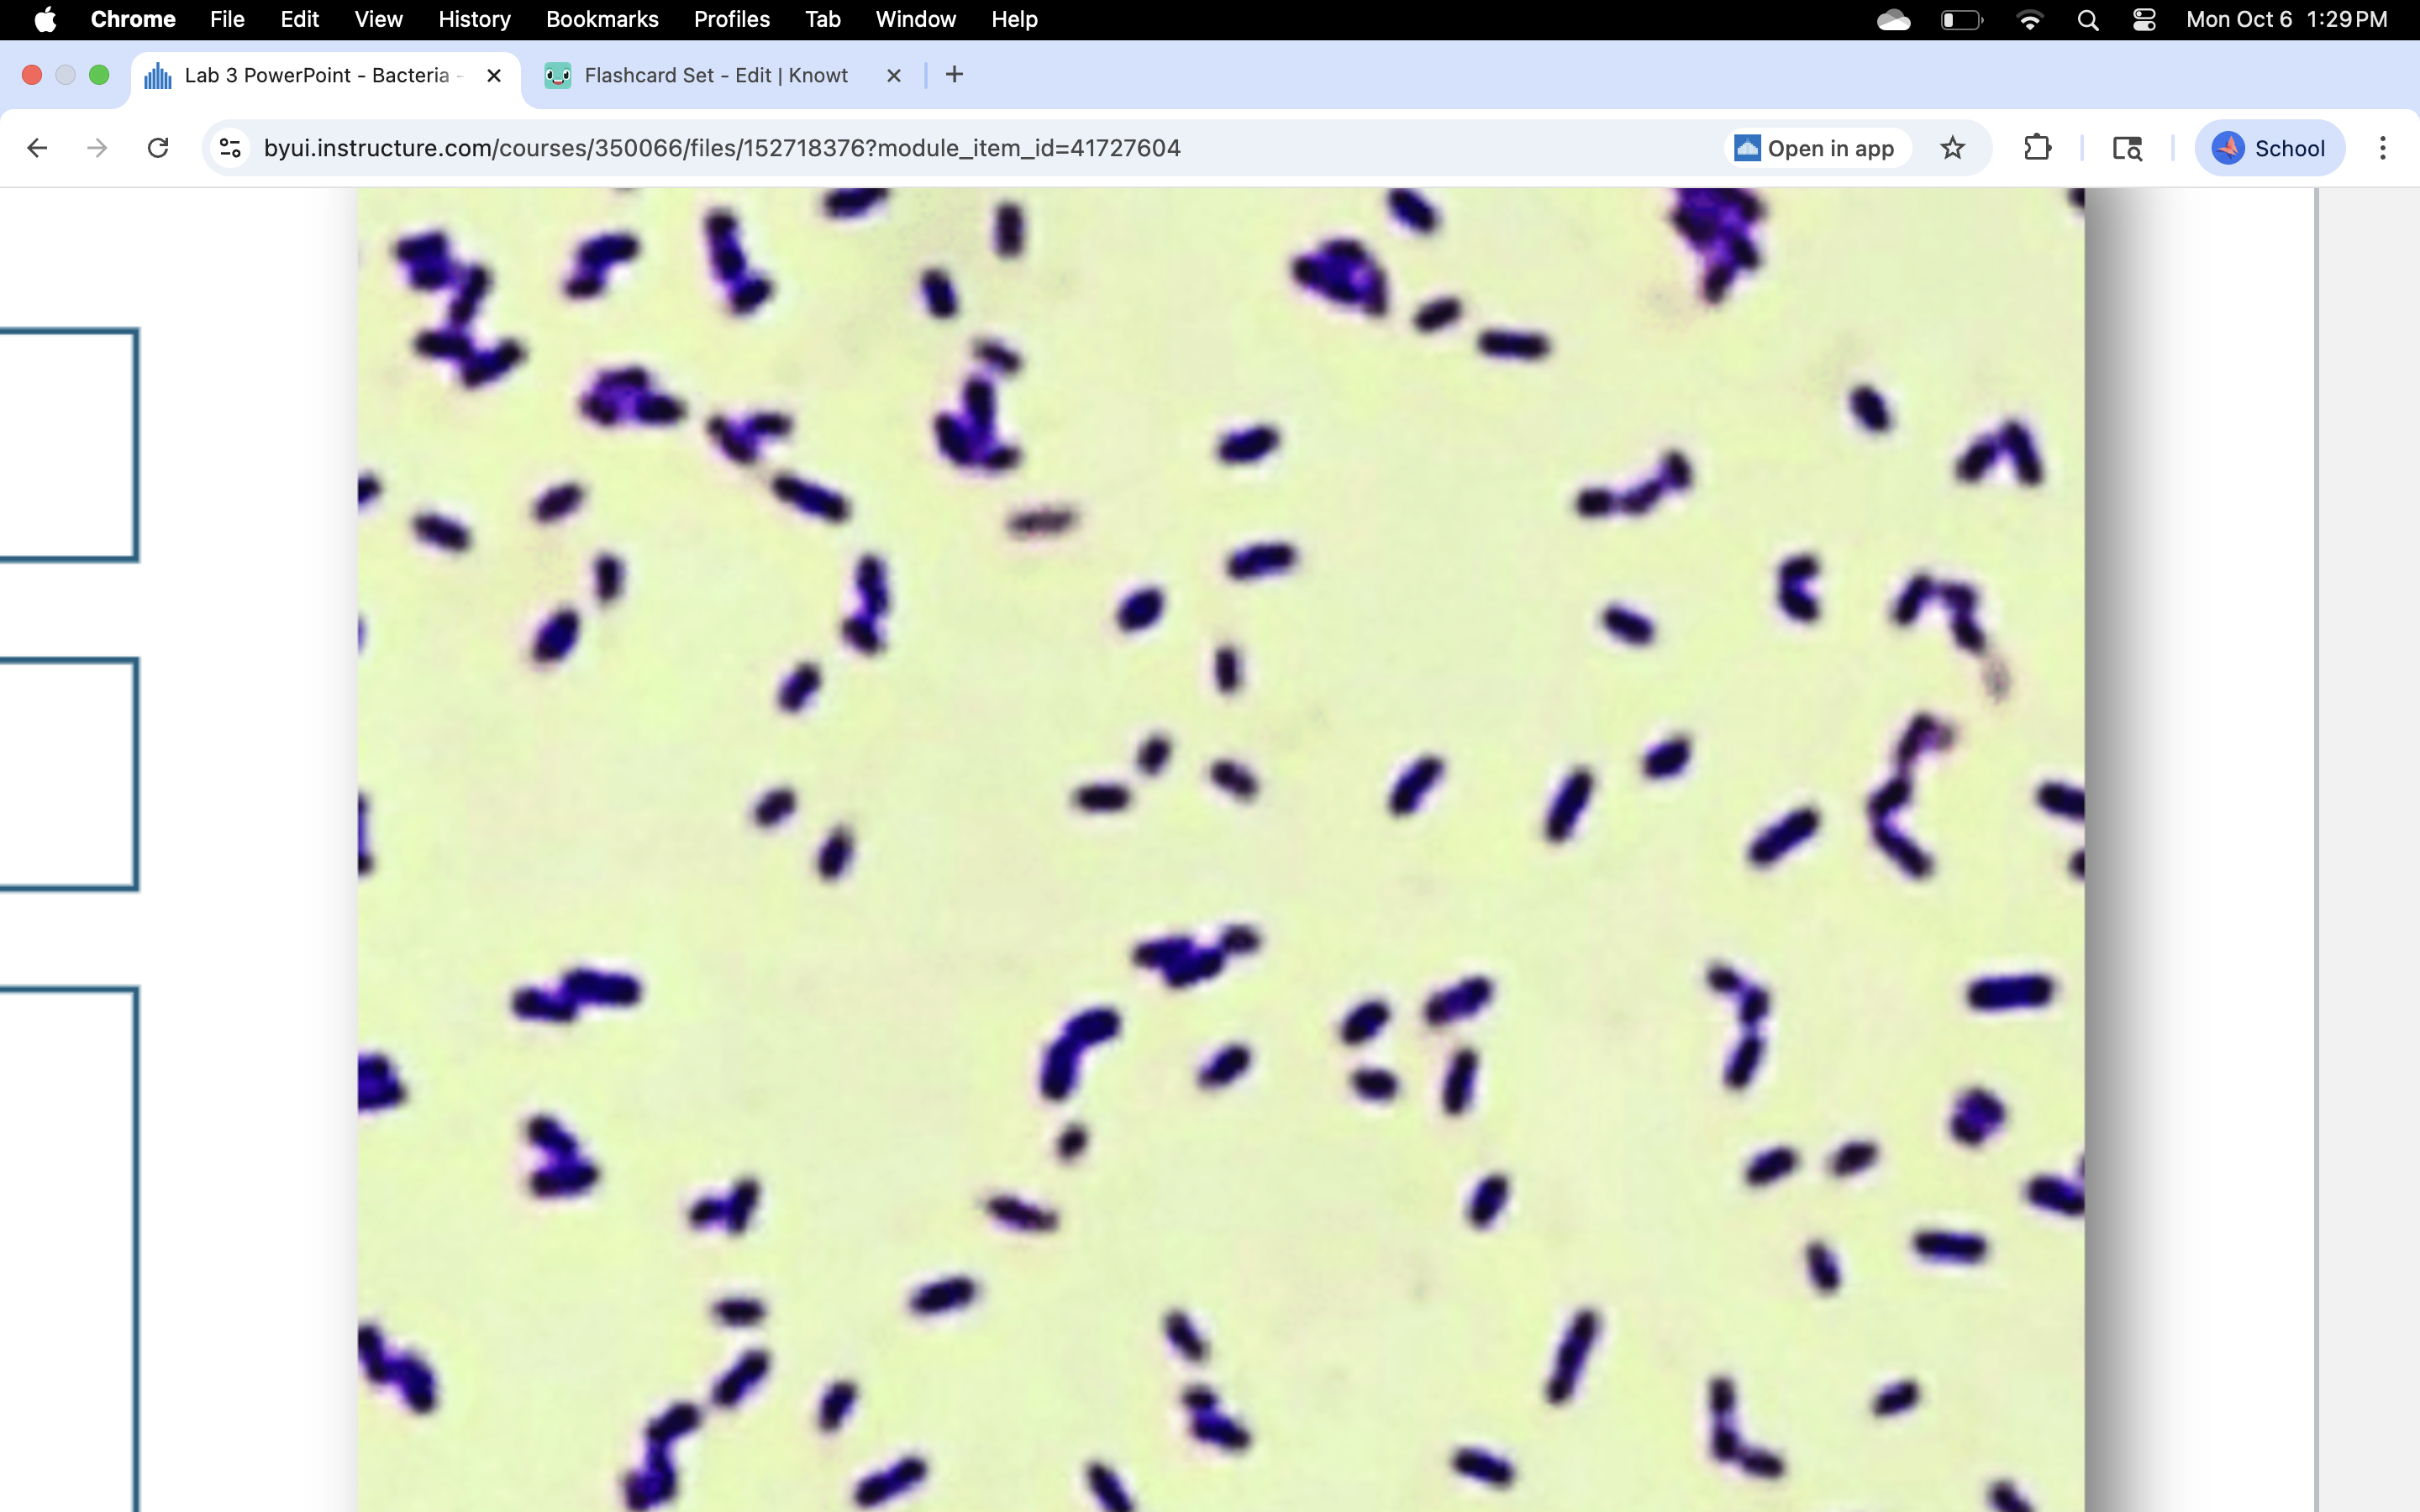
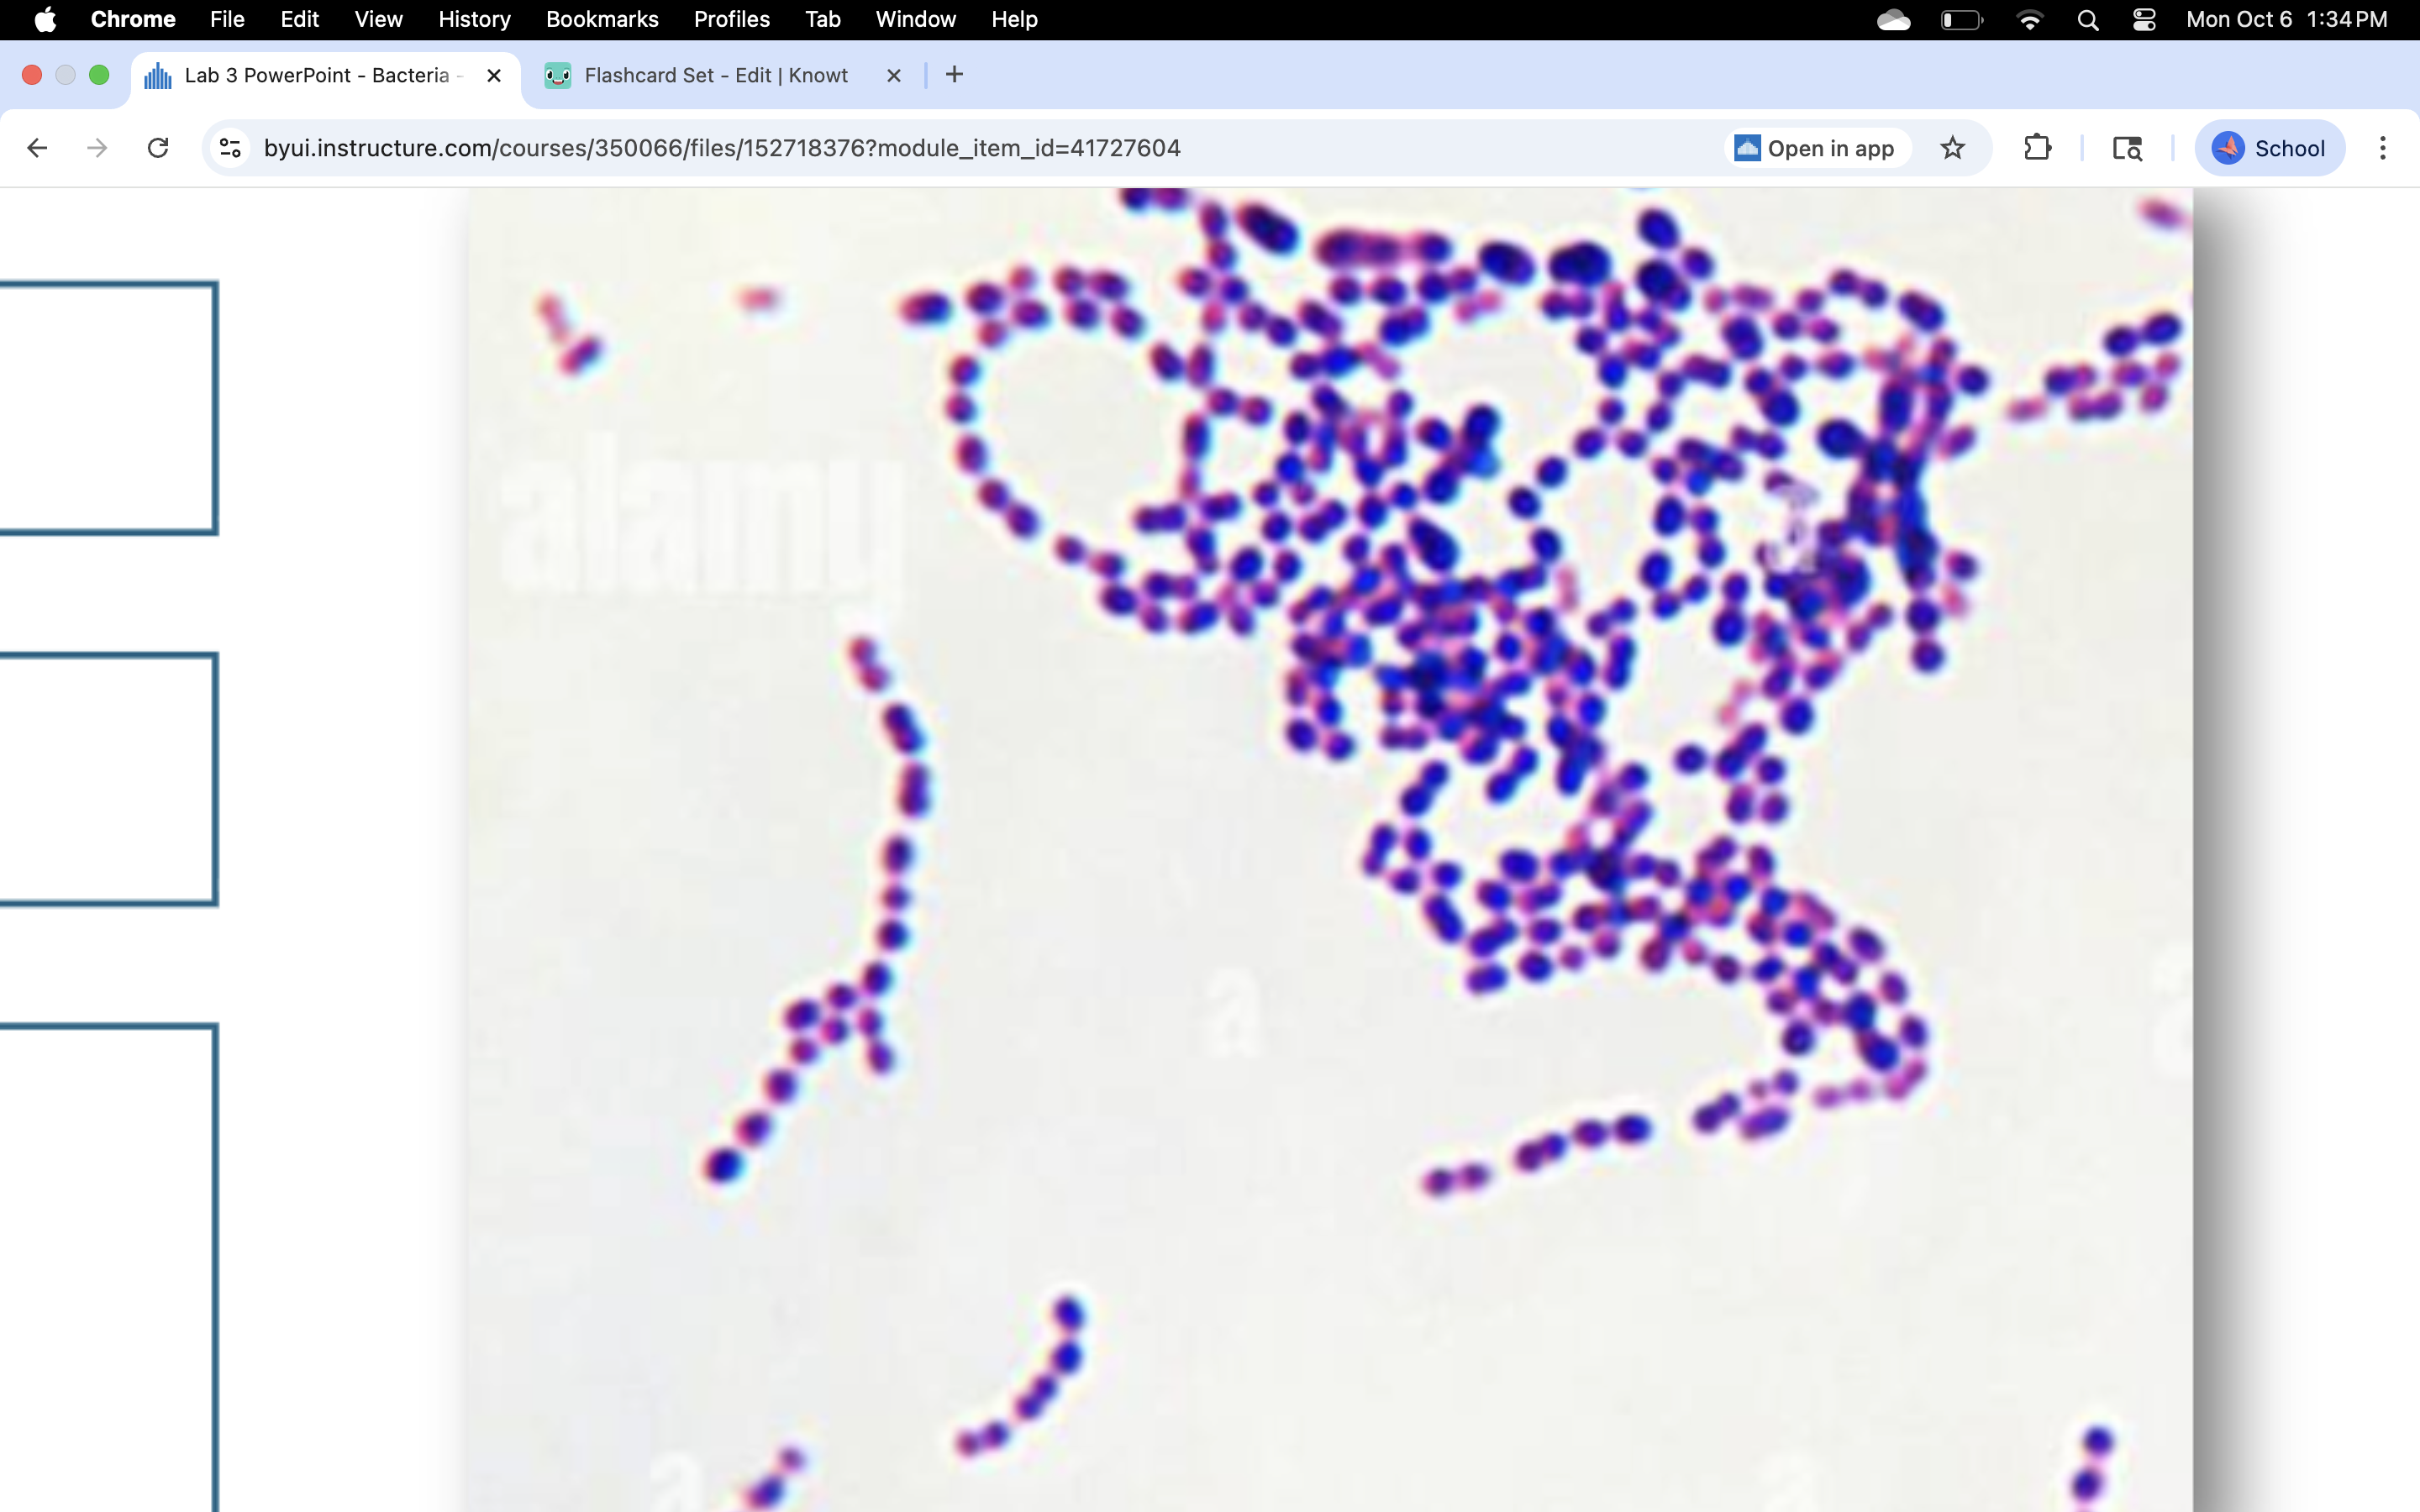
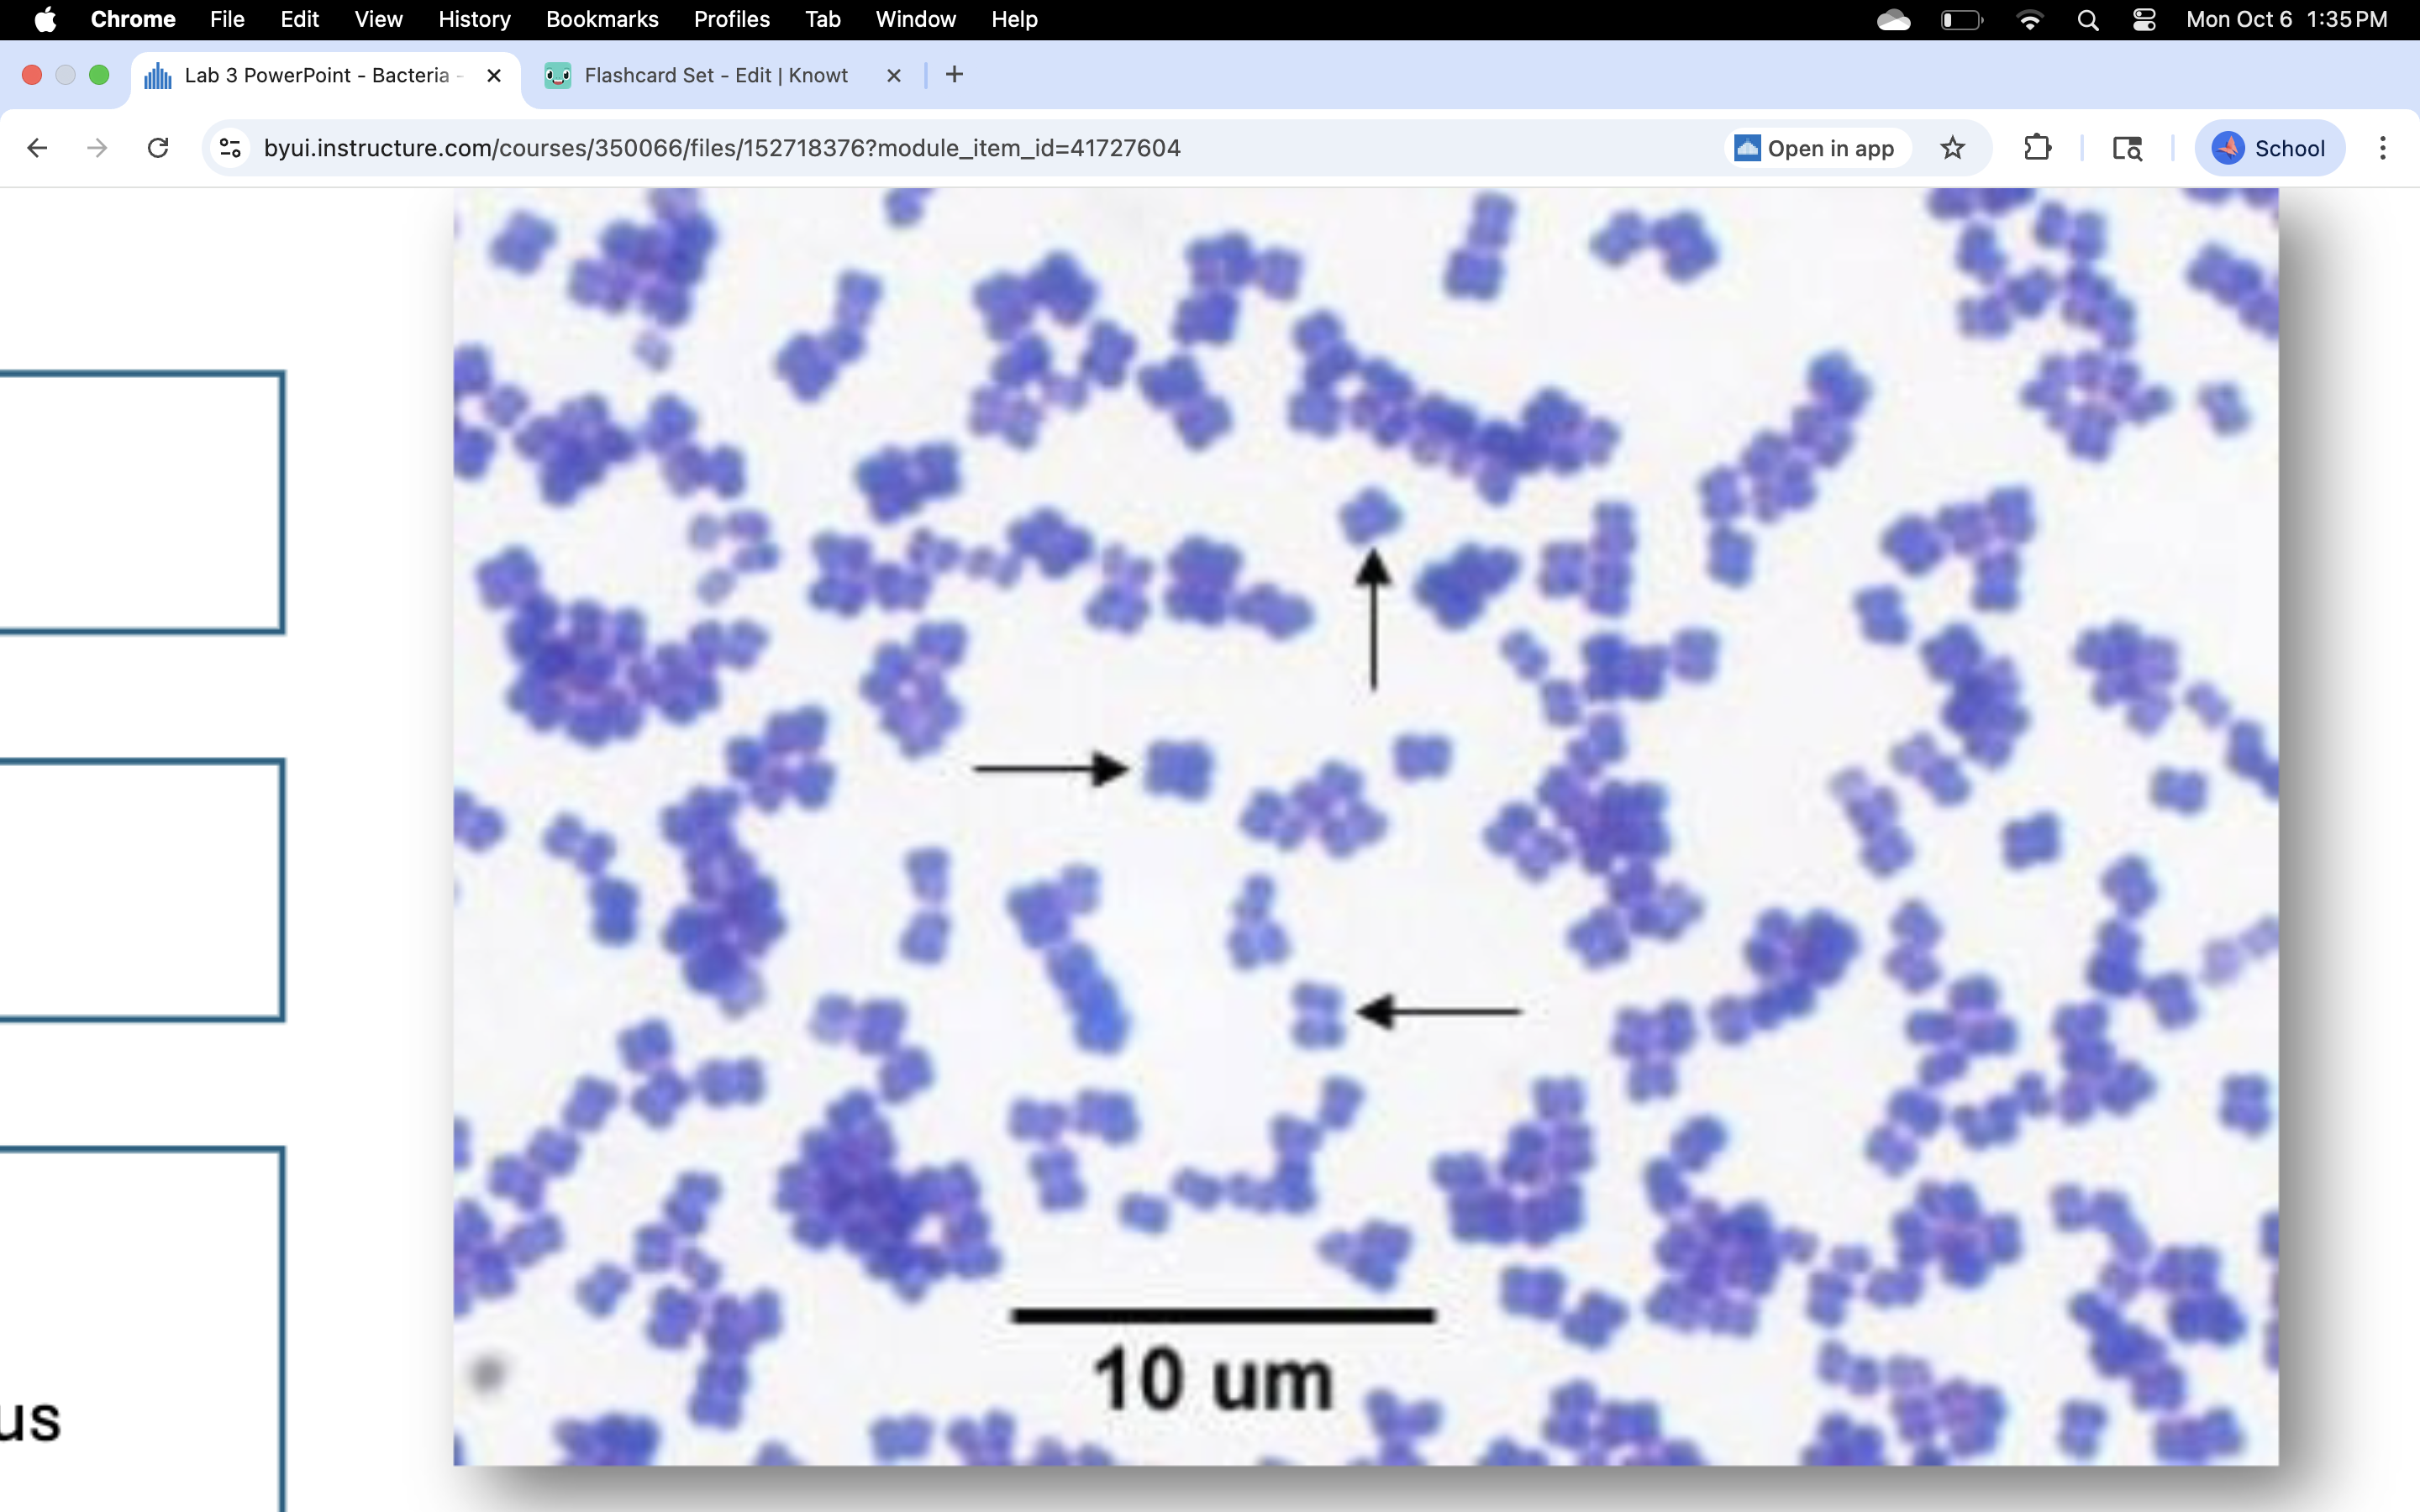

1/35
Looks like no tags are added yet.
Name | Mastery | Learn | Test | Matching | Spaced | Call with Kai |
|---|
No analytics yet
Send a link to your students to track their progress
staphylococcus aureus
-human normal flora
-toxic shock syndrome
-food poisoning
-skin infections
-gram + cocci
staphylococcus aureus
-human normal flora
-toxic shock syndrome
-food poisoning
-skin infections
-gram + cocci
clostridium botulinum
-gram + single bacillus
-endospores at the end
-make botulinum toxin
-cause flacid paralysis
clostridium botulinum
-gram + single bacillus
-endospores at the end
-make botulinum toxin
-cause flacid paralysis

cornynebacterium diphtheriae
-gram + bacillus
-with metachromatic granules
-cause diptheria
cornynebacterium diphtheriae
-gram + bacillus
-with metachromatic granules
-cause diptheria

listeria monocytogenes
-gram + bacillus
-grow at fridge temp
-in deli meat and animal product
-bad for prego mom and immunocompromised
-cause meningitis
-and septicemia
listeria monocytogenes
-gram + bacillus
-grow at fridge temp
-in deli meat and animal product
-bad for prego mom and immunocompromised
-cause meningitis
-and septicemia
neisseria gonorrhoeae
-gram - diplococci
-cause gonorrhea, salpingitis and opthalmia in newborn
-found intracellular and extracellular
neisseria gonorrhoeae
-gram - diplococci
-cause gonorrhea, salpingitis and opthalmia in newborn
-found intracellular and extracellular

streptococcus pyogenes
-gram + streptococci
-group A streptococci (GAS)
-strep infections
-strep throat, rheumatic fever, glomerulonephritis, scarlet fever, erysipelas, puerperal sepsis
streptococcus pyogenes
-gram + streptococci
-group A streptococci (GAS)
-strep infections
-strep throat, rheumatic fever, glomerulonephritis, scarlet fever, erysipelas, puerperal sepsis
micrococcus luteus
-gram + sarcinae
-nonpathogenic
-in environment
-nromal microbiota of human on skin mucous membrane and oropharynx
micrococcus luteus
-gram + sarcinae
-nonpathogenic
-in environment
-nromal microbiota of human on skin mucous membrane and oropharynx
streptococcus pneumoniae
-Gram + streptococcus
-most common cause pneumonia
-otitis media, sinus infections and eye infections
-common cause meningitis
streptococcus pneumoniae
-Gram + streptococcus
-most common cause pneumonia
-otitis media, sinus infections and eye infections
-common cause meningitis

bacillus anthracis
-highly pathogenic
-cause anthrax
-transmitted through animals or contaminated animal products
-central endospore
bacillus anthracis
-highly pathogenic
-cause anthrax
-transmitted through animals or contaminated animal products
-central endospore

escherichia coli
-Gram - bacilli
-rapidly divide so some cells are short
-in lg intesting of warm blood animals
-cause UTI and septicemia and hemorrhagic diarrhea
-indicator pathogent ( determines presence of other pathogens)
escherichia coli
-Gram - bacilli
-rapidly divide so some cells are short
-in lg intesting of warm blood animals
-cause UTI and septicemia and hemorrhagic diarrhea
-indicator pathogent ( determines presence of other pathogens)

salmonella species
-gram - bacillus
-resistant to environmental extremes
-normal flora in poultry, reptiles and animals
-shed by feces
cause typhoid fever bacteremia and enterocolitis
salmonella species
-gram - bacillus
-resistant to environmental extremes
-normal flora in poultry, reptiles and animals
-shed by feces
cause typhoid fever bacteremia and enterocolitis

klebsiella pneumoniae
-gram -
-capsule stain bc of thick capsule
-in normal flora of GI tract
-cause pneumonia, UTI and septicemia
klebsiella pneumoniae
-gram -
-capsule stain bc of thick capsule
-in normal flora of GI tract
-cause pneumonia, UTI and septicemia

pseudomonas aeruginosa
-gram - bacilli
-grape like odor or corn chip
-opportunist pathogen
-hospital infections like burn, respiratory, UTI, wound, bacteremia
-resistant to antibiotics and disinfectants
pseudomonas aeruginosa
-gram - bacilli
-grape like odor or corn chip
-opportunist pathogen
-hospital infections like burn, respiratory, UTI, wound, bacteremia
-resistant to antibiotics and disinfectants

haemophilus influenzaae
-gram - coccobacillus
-small pleomorphic
-normal flora of upper respiratory tract
-cause sinusitis otitis media, pheumonia, bronchitis
-elderly and immunocompromised susceptible
haemophilus influenzaae
-gram - coccobacillus
-small pleomorphic
-normal flora of upper respiratory tract
-cause sinusitis otitis media, pheumonia, bronchitis
-elderly and immunocompromised susceptible

helicobacter pylori
-gram - spirillum
-gastric duodenal and peptic ulcers
-infection to gastric carcinoma
helicobacter pylori
-gram - spirillum
-gastric duodenal and peptic ulcers
-infection to gastric carcinoma

campylobacter species
-gram - spiral bacillis
-seagull shape
-bacterial diarrhea
-from contaminated food or chickens or pets
campylobacter species
-gram - spiral bacillis
-seagull shape
-bacterial diarrhea
-from contaminated food or chickens or pets

vibrio species
-gram - vibrio
-flagellated
-cholera, septicemia, gastroenteritis, water associated wound infections
-in estuaries and seafood
vibrio species
-gram - vibrio
-flagellated
-cholera, septicemia, gastroenteritis, water associated wound infections
-in estuaries and seafood

treponema pallidum
-gram - spirochete
-axial filaments
-syphilis and neurosyphilis
treponema pallidum
-gram - spirochete
-axial filaments
-syphilis and neurosyphilis
